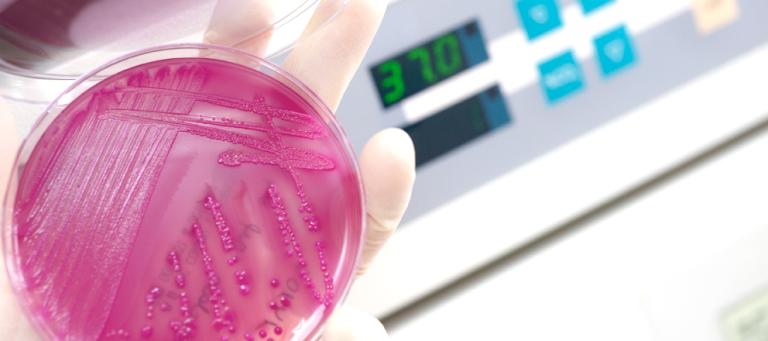

Effect of vaccination on protection against RHDV-2 and viral load
สิ่งตีพิมพ์
กระต่าย
ที่ปรากฏใน
SVEPM Conference, 2018
The aim of this study was to assess the clinical course, viral load, survival rate and humoral immune response of animals vaccinated with ERAVAC® after experimental RHDV2 infection at 6 months post-vaccination.
ดาวน์โหลดบทความ